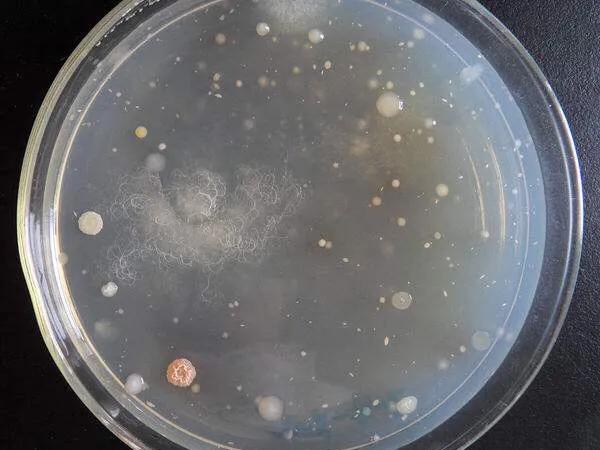
天文望远镜保养,olimtms望远镜保养

有时候对于闲置的望远镜来说,如果长时间放在潮湿的环境里就很容易滋生霉菌。天气干燥还好,特别是在梅雨季节,一不小心心爱的镜子就发霉了,轻者损伤镀膜,重则导致镜子报废。那么我们该如何保养防止镜头发霉呢?
一些望远镜通过采用充氮防水设计来提高望远镜的耐用性,延长他们的使用寿命,用干燥氮气的保护望远镜内部棱镜组,使水汽和尘埃都无法进入望远镜的内部。所以一般*用军**望远镜(95式)或一些民用望远镜会采用充氮防水的设计,使望远镜在潮湿环境下保持干燥,防止壁面镜片生霉菌。

在使用过程中,如果发现镜片上有灰尘或者痕迹,切忌切勿用水擦洗。应该先用吹气球(摄影器材店有售)或医用洗耳球(药店有售)吹去,同时注意一定不要用嘴去吹,因为这可能导致唾液或灰尘落在镜面上,增加工作量。吹不掉可尝试用脱脂棉签沾无水酒精或*醚乙**酒精混合液,注意别蘸取太多液体,以免流入望远镜内部,特别是一些没有充氮密封的望远镜。手法为从中心向外向擦拭,也可以用镜笔,镜笔的软皮垫可以轻易地擦掉镜片上的水迹和手印,而且几乎不留痕迹,对于初起霉斑的清洁效果非常好。要注意的是如果镜面上有水或厚重的潮气,要等干透后在用镜笔清洁。

擦拭时切忌直接干擦,这会导致镀膜的损伤,一些常见的用来清洁镜头的工具,如镜头纸等,使用过程中容易在镜头上留下轻微的划痕,所以不是很推荐。在学会清理镜片这一关一定注意细节,要记住不可以经常擦,清洁应该是在不得已的情况下,所以以下几点就尤为重要。
1.为避免有灰尘掉落在镜片上,用完望远镜时要及时盖上物镜盖及目镜盖。
2.不要用手去摸镜片,避免镜片上沾染油脂指纹等影响成像清晰度以及后续清理。
3.不要将望远镜放在烈日下的汽车中或阳光下长时间暴晒,防止高温加速橡胶的老化。
4.望远镜应保存在干燥的环境中,不定时拿出来通通风。
对望远镜感兴趣的朋友可以在底下留言评论,小编也会不定时进行分享更新。